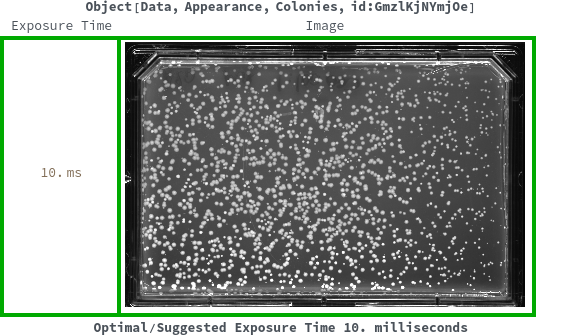

PlotImageExposure
PlotImageExposure[ExposureAnalysis]⟹Plot
generates a graphical representation of the reference images from ExposureAnalysis.
PlotImageExposure[ColoniesAppearanceData]⟹Plot
generates a graphical representation of the images used in ImageExposureAnalyses field from ColoniesAppearanceData.
Details
-
AnalysisNotFound No image exposure analysis with ImageType `2` was found for the input data `1`. Please use AnalyzeImageExposure to calculate the gray-values for your images beforehand. ConflictingImageTypes The ImageType recorded with for the input data `1` is `2` while option ImageType is set to `3`. Please adjust the ImageType option or let it resolve automatically. ImageNotFound No image was found with ImageType `2` for the input data `1`.
Input

Output

General Options

Messages
Examples
Basic Examples (5)
Plot images over exposure times when multiple exposure times are recorded from analysis object:


Plot images over exposure times when multiple exposure times are recorded from appearance object:


Plot image when a single exposure time is recorded from analysis object:


Plot image when a single exposure time is recorded from appearance object:

Plot lane images when the reference is PAGE data:


Last modified on Wed 23 Oct 2024 14:53:33